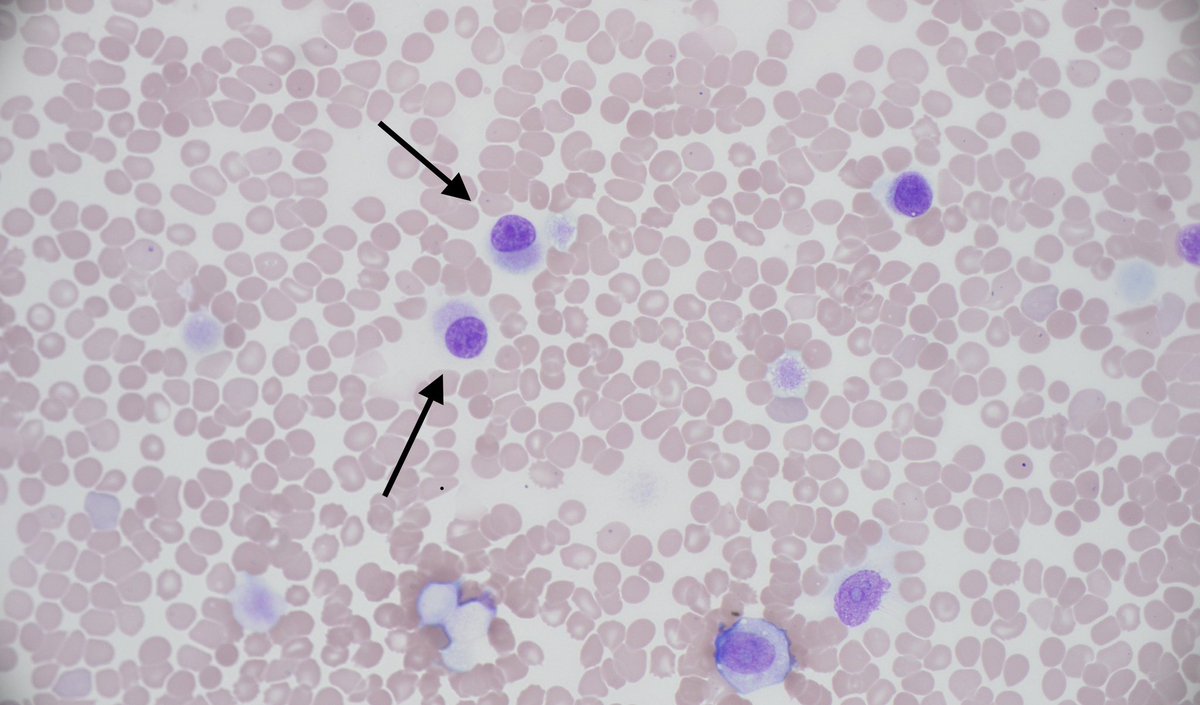
Brooj Abro, MD tweet media

Ffernandes_MD retweetledi

The serum free light chain FLC assay. Tutorial. #MedTwitter #MyelomaVR
Frequently ordered and frequently abnormal. This thread will reduce unnecessary headaches and referrals.
1/ Don’t order it unless you are suspecting myeloma, amyloid or related disorder
English